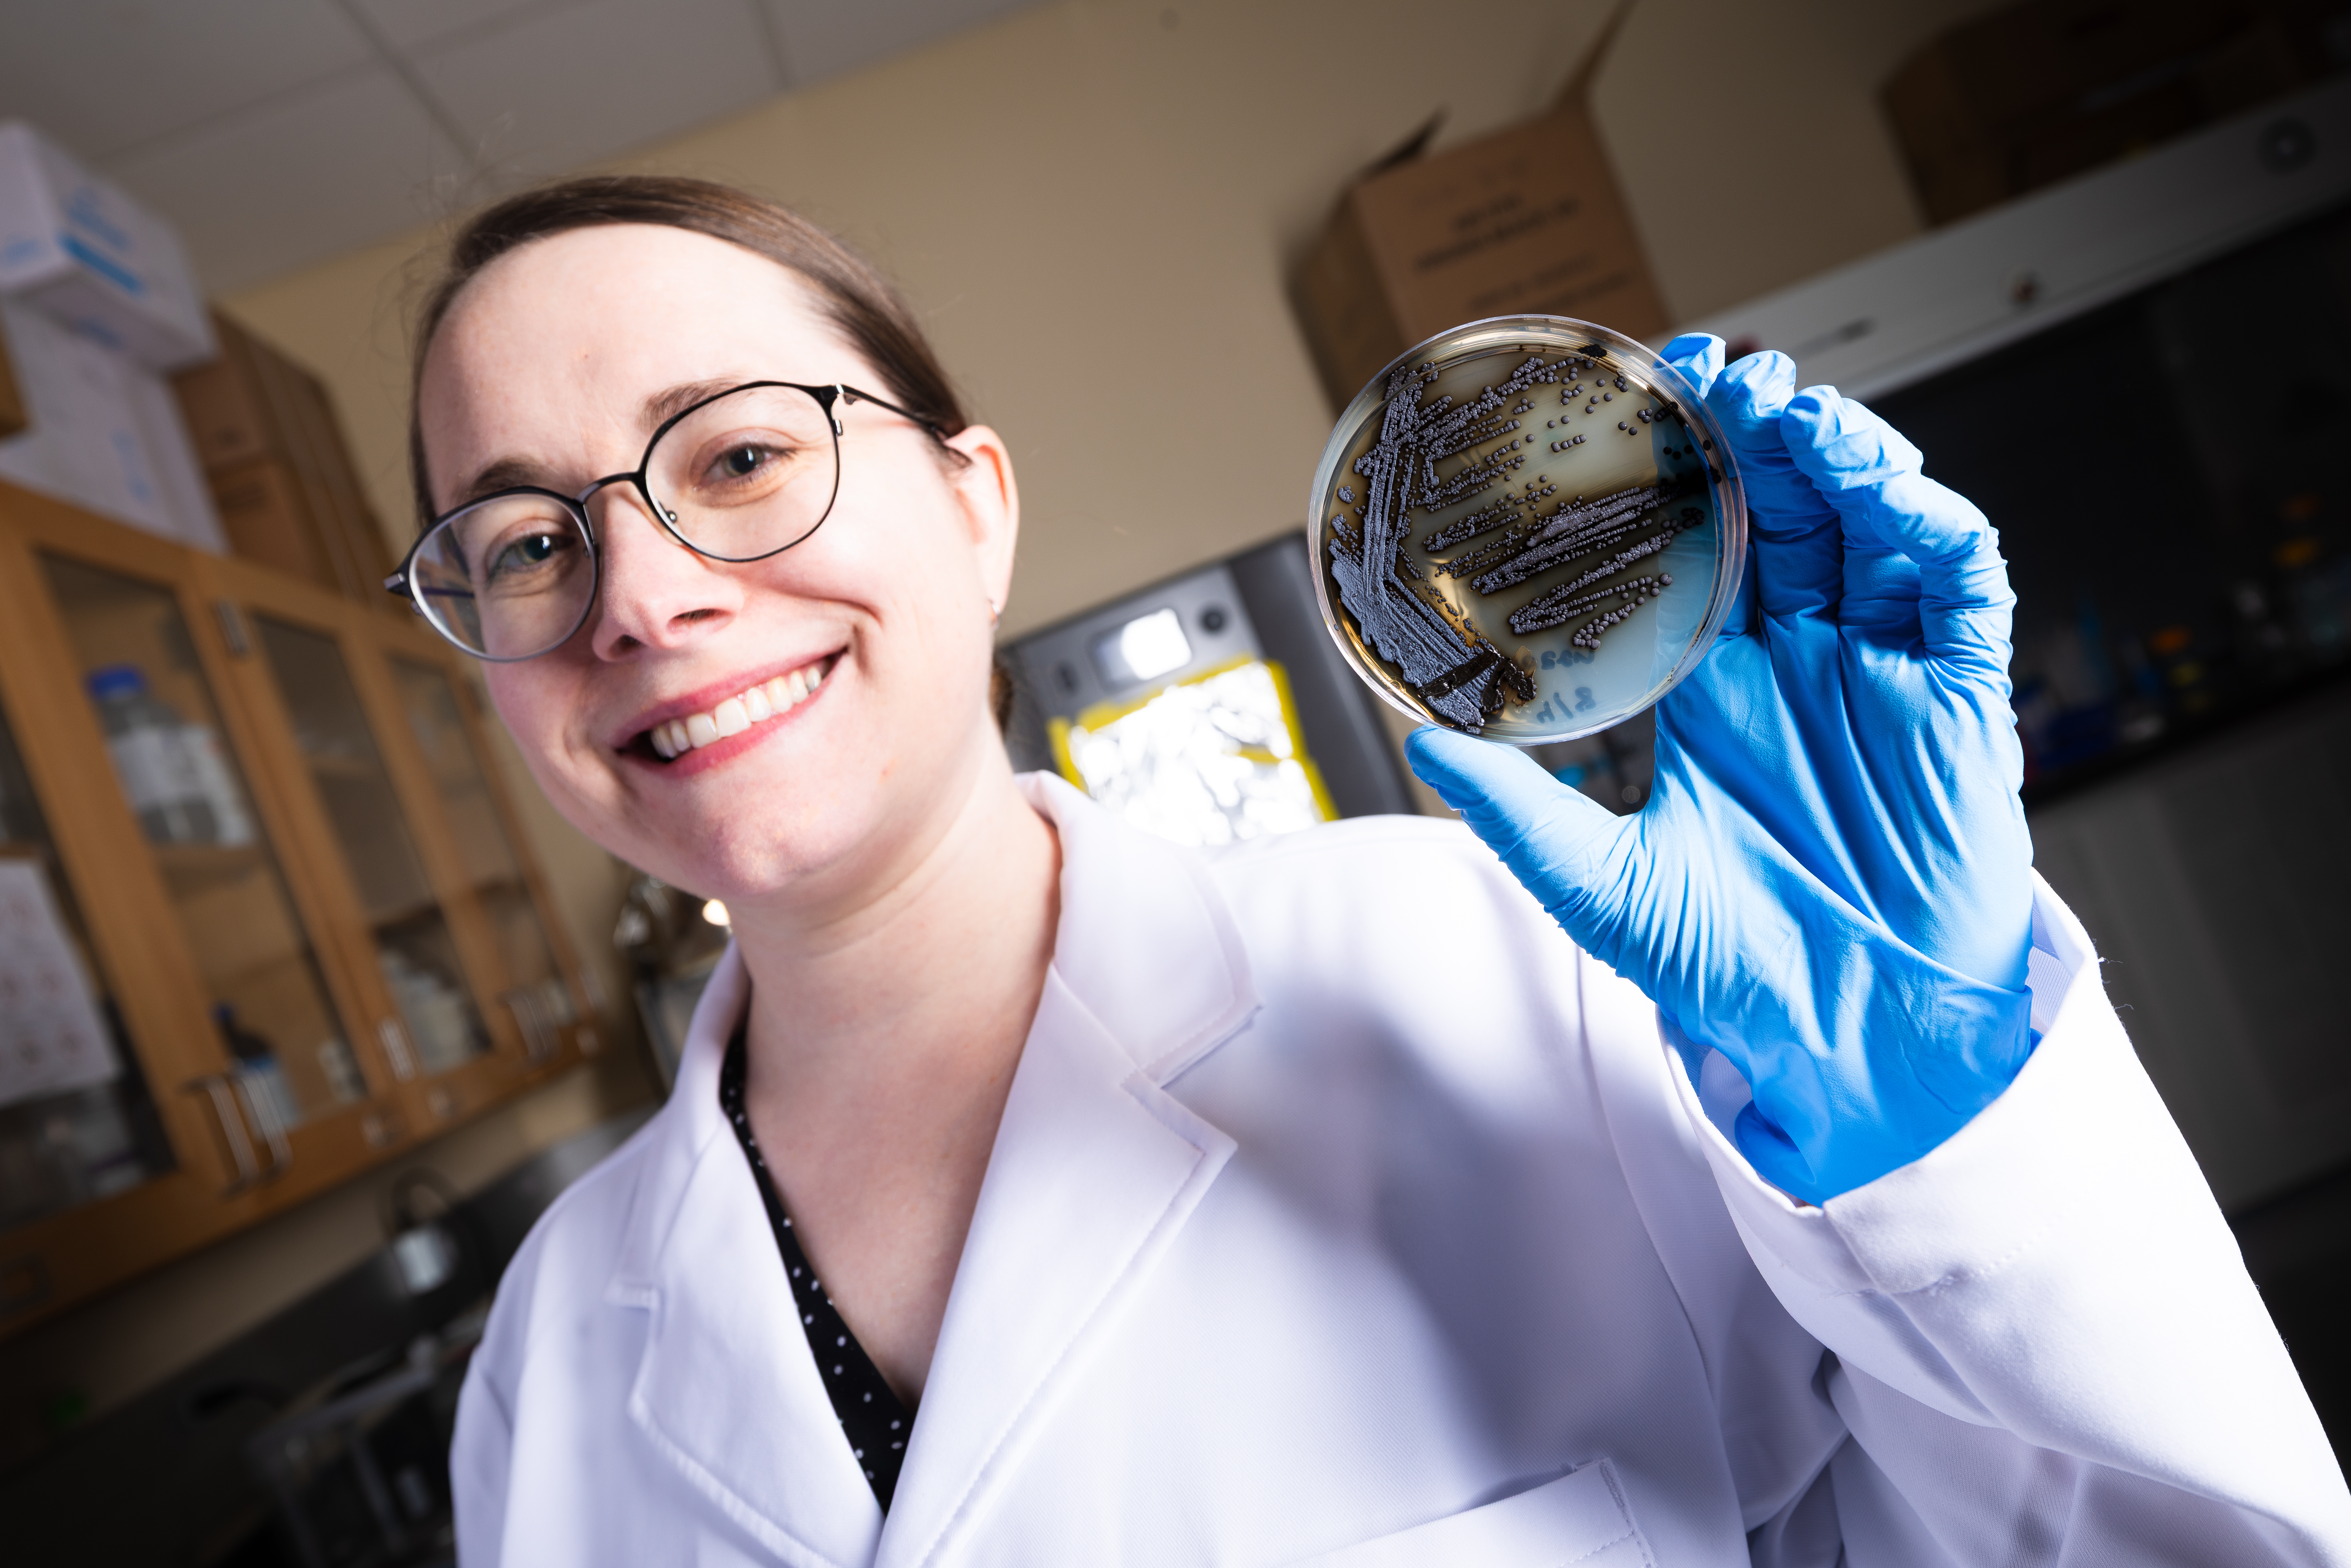

Erin C. Carr
Ph.D. in Biology
I am a postdoctoral fellow at the University of Nebraska-Lincoln in the Department of Chemical and Biomolecular Engineering. Here, I focus on the ecological microbiology of melanized fungi, algae, and cyanobacteria. My research interests include identifying new fungal taxa, understanding the biomolecular processes and regulations that enable melanized fungi to thrive in diverse ecosystems and lifestyles, and exploring how melanin production by these organisms can be harnessed for anthropologic applications.
I have extensive experience in studying non-model organisms and culturing new organisms. My expertise encompasses developing assays for metabolic phenotyping and applying genetic and molecular methods across various applications. Furthermore, I have a strong background in laboratory management and upkeep. I have also had the privilege of mentoring several undergraduate researchers, guiding them in various aspects of my work as well as their individual research projects.